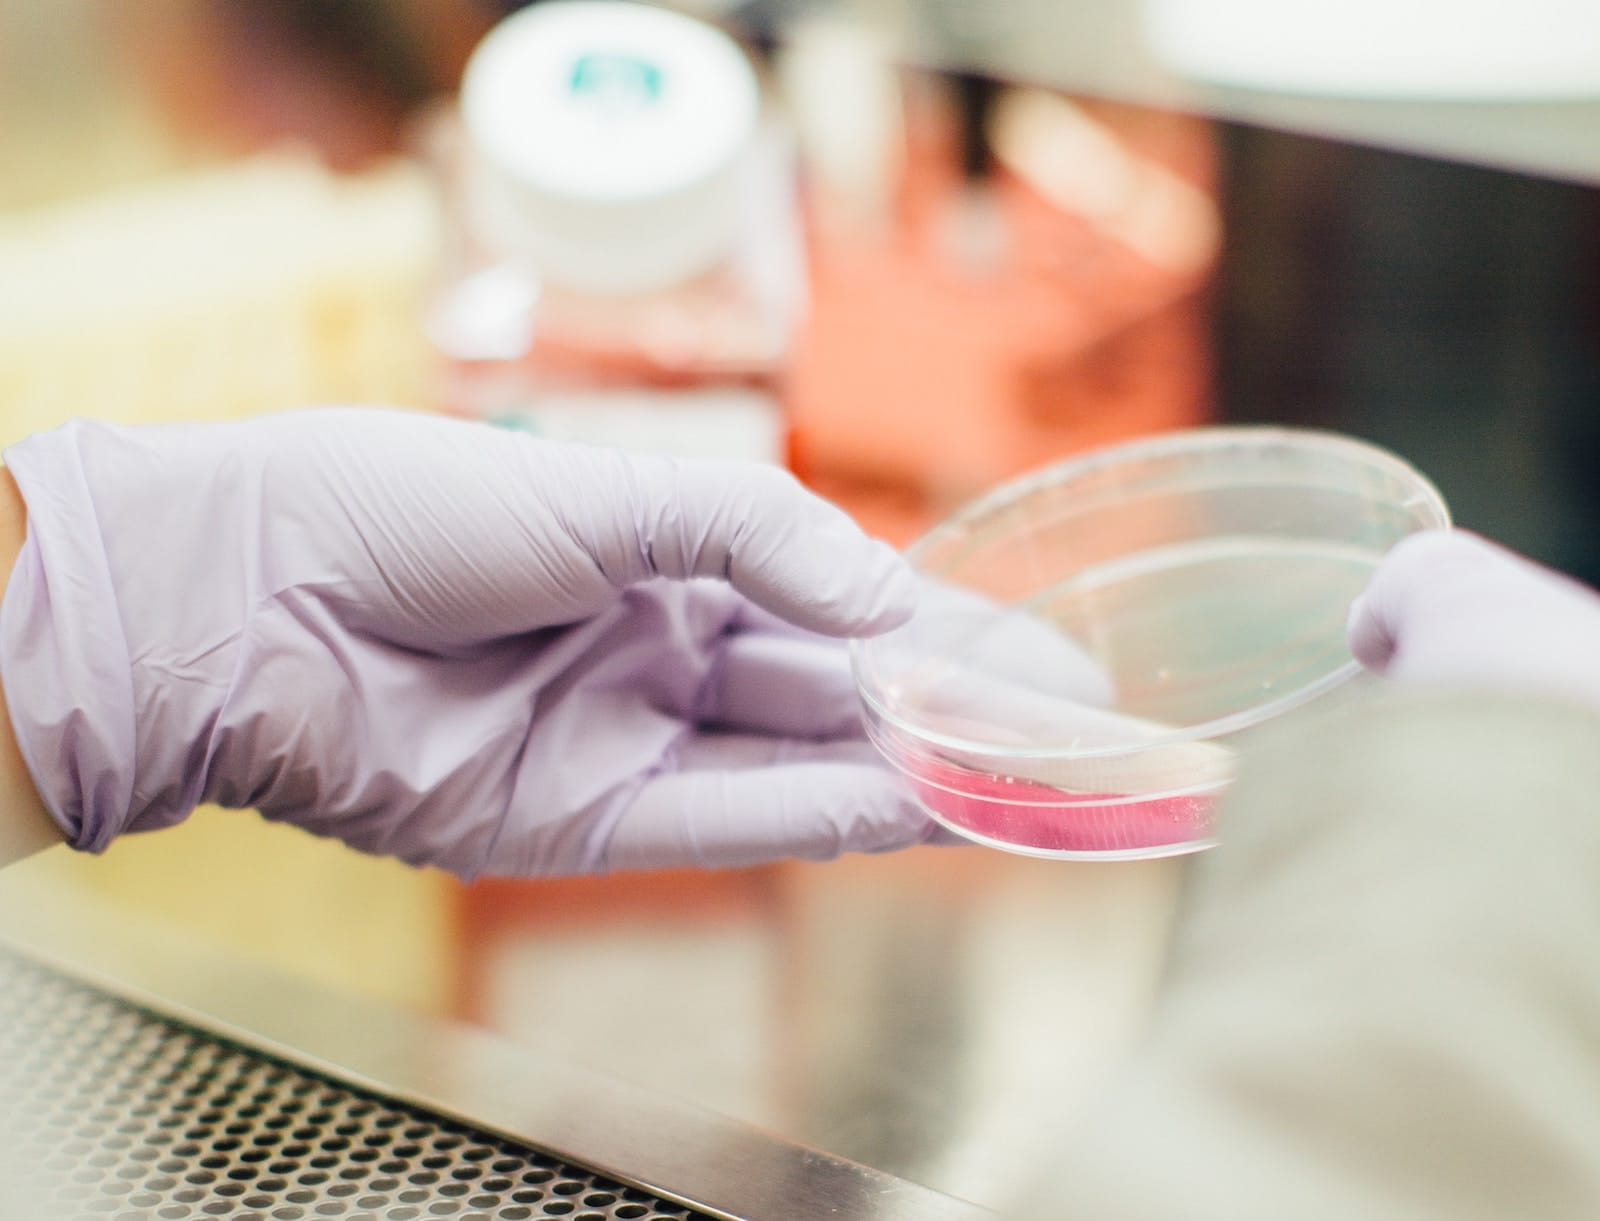

Tre biomarcatori, impiegati insieme, sono in grado di fornire un potente strumento di predizione del destino dei pazienti con scompenso cardiaco, per valutare la probabilità di ospedalizzazione. Lo rivela uno studio dei ricercatori della Scuola Superiore Sant’Anna di Pisa e della Fondazione Toscana Gabriele Monasterio con gli studiosi dei più importanti centri di ricerca europei e americani pubblicato su una rivista cardiologica Journal of the American College of Cardiology.
I ricercatori italiani hanno dimostrato che il dosaggio ematico di tre biomarcatori (il recettore solubile Sst2, l’ormone cardiaco Nt-probnp e la proteina cardiaca troponina T dosata con metodiche ad alta sensibilità) possono fornire risposte decisive in termini predittivi. Lo studio ha analizzato i dati di oltre 4mila pazienti attraverso metodiche statistiche avanzate ed è emerso che il dosaggio dei tre biomarcatori consente quindi di adattare la strategia terapeutica sulla base del rischio individuale di ogni singolo paziente consentendo di individuare gruppi a rischio elevato, intermedio, basso e di modulare di conseguenza la terapia connessa e la frequenza del follow-up.
“L’osservazione è assolutamente originale – sottolineano i cardiologi Michele Emdin e Claudio Passino – e ha avuto ampia risonanza nel mondo cardiologico internazionale. I risultati pubblicati confermano il valore della combinazione fra i tre biomarcatori per la valutazione integrata del paziente cardiopatico e la messa a punto di nuovi strumenti di diagnosi e cura di una delle patologie più frequenti e pericolose”.